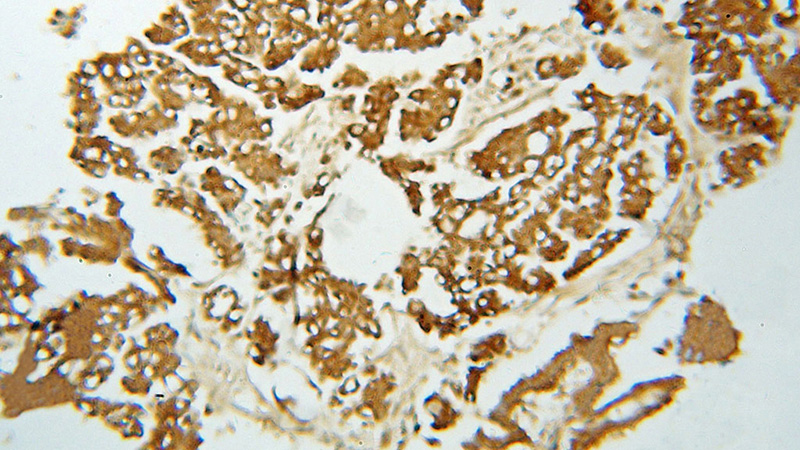
Immunohistochemical of paraffin-embedded human ovary tumor using Catalog No:108843(CAPZA1 antibody) at dilution of 1:50 (under 10x lens)

-
Product Name
CAPZA1 antibody
- Documents
-
Description
CAPZA1 Rabbit Polyclonal antibody. Positive IHC detected in human ovary tumor tissue, human pancreas cancer tissue. Positive IP detected in SH-SY5Y cells. Positive WB detected in human brain tissue. Observed molecular weight by Western-blot: 33kd
-
Tested applications
ELISA, WB, IHC, IP
-
Species reactivity
Human,Mouse,Rat; other species not tested.
-
Alternative names
CAPPA1 antibody; CAPZ antibody; CapZ alpha 1 antibody; CAPZA1 antibody; CAZ1 antibody
-
Isotype
Rabbit IgG
-
Preparation
This antibody was obtained by immunization of CAPZA1 recombinant protein (Accession Number: NM_006135). Purification method: Antigen affinity purified.
-
Clonality
Polyclonal
-
Formulation
PBS with 0.1% sodium azide and 50% glycerol pH 7.3.
-
Storage instructions
Store at -20℃. DO NOT ALIQUOT
-
Applications
Recommended Dilution:
WB: 1:200-1:2000
IP: 1:200-1:1000
IHC: 1:20-1:200
-
Validations

human brain tissue were subjected to SDS PAGE followed by western blot with Catalog No:108843(CAPZA1 antibody) at dilution of 1:400
Immunohistochemical of paraffin-embedded human ovary tumor using Catalog No:108843(CAPZA1 antibody) at dilution of 1:50 (under 10x lens)

Immunohistochemical of paraffin-embedded human ovary tumor using Catalog No:108843(CAPZA1 antibody) at dilution of 1:50 (under 40x lens)

IP Result of anti-CAPZA1 (IP:Catalog No:108843, 4ug; Detection:Catalog No:108843 1:300) with SH-SY5Y cells lysate 3000ug.
-
Background
CAPZA1 (F-actin-capping protein subunit alpha-1) is a member of the F-actin capping protein alpha subunit family and regulates actin filament growth, stability and disassembly. Differential expression of CAPZA1 has been found in gastric cancer and melanoma, indicating its possible role in tumorigenesis. (21566537, 23545944)
-
References
- Lee YJ, Jeong SH, Hong SC. Prognostic value of CAPZA1 overexpression in gastric cancer. International journal of oncology. 42(5):1569-77. 2013.
- Gemoll T, Roblick UJ, Szymczak S. HDAC2 and TXNL1 distinguish aneuploid from diploid colorectal cancers. Cellular and molecular life sciences : CMLS. 68(19):3261-74. 2011.
- Sun D, Zhou M, Kowolik CM. Differential expression patterns of capping protein, protein phosphatase 1, and casein kinase 1 may serve as diagnostic markers for malignant melanoma. Melanoma research. 21(4):335-43. 2011.
- Linge A, Kennedy S, O'Flynn D. Differential expression of fourteen proteins between uveal melanoma from patients who subsequently developed distant metastases versus those who did Not. Investigative ophthalmology & visual science. 53(8):4634-43. 2012.
Related Products / Services
Please note: All products are "FOR RESEARCH USE ONLY AND ARE NOT INTENDED FOR DIAGNOSTIC OR THERAPEUTIC USE"
